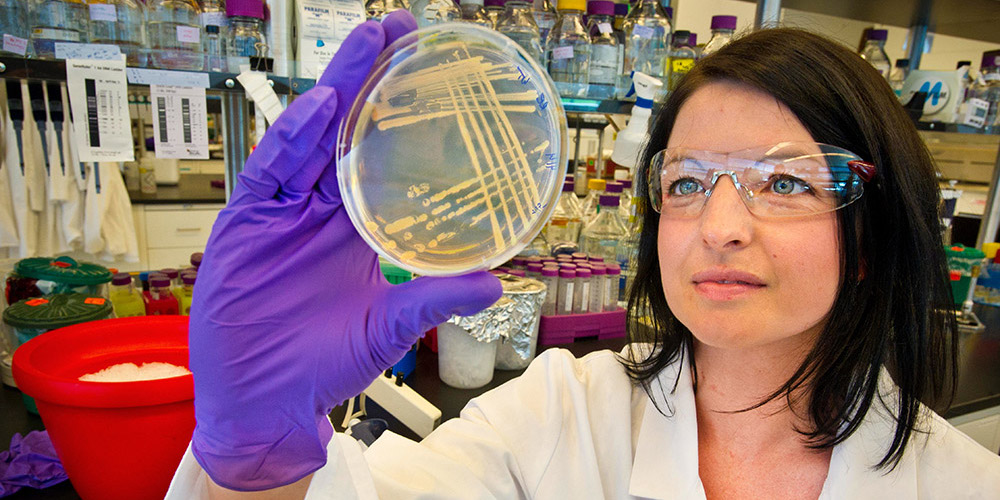
30 noviembre: El SARS-CoV-2 puso a prueba las capacidades globales de la ciencia y la biotecnología. Con Andrés Moreira Soto y Martina Nibbeling-Wriessnig.

El SARS-CoV-2 abrió múltiples vertientes de investigación que producen resultados que a su vez modifican decisiones de política pública con impresionante vertiginosidad. Inicialmente estudiado a partir de la secuencia genética de su predecesor, el Sars1, en cuanto se encontraron las claves del nuevo virus, el mundo se abocó a buscar respuestas. De eso hace apenas 11 meses. Hoy sabemos mucho más, estamos a punto de tener vacunas para empezar la inmensa tarea de la inoculación global, pero a las tareas de investigación, intercambio de buenas prácticas, modernización de procedimientos y cooperación internacional les queda un inacabable camino por delante. Después de todo en cualquier momento podría aparecer un nuevo virus.
Por eso la diplomacia se mueve en dirección de la ciencia. Un equipo de seis expertos del denominado Equipo Alemán de Intervención Rápida en Salud que está apoyando el desarrollo de capacidades de pruebas diagnósticas de Covid-19 en África y América, llegó este fin de semana al país justamente como pie de apoyo para nuestro Instituto Costarricense de Investigación y Enseñanza en Nutrición y Salud (INCIENSA).
Además de traer una donación de 50 mil pruebas de PCR, la misión apoya el equipamiento de los laboratorios del INCIENSA y provee intercambios de alto nivel científico en temas sustantivos que permitan fortalecer las capacidades diagnósticas del país. Conversamos con uno de los expertos de la misión, el costarricense Andrés Moreira Soto, virólogo del reconocido Hospital Charité de Berlín, uno de los laboratorios de referencia para Covid-19 de la Organización Mundial de la Salud. También nos acompaña la Embajadora de Alemania, Martina Nibbeling-Wriessnig.